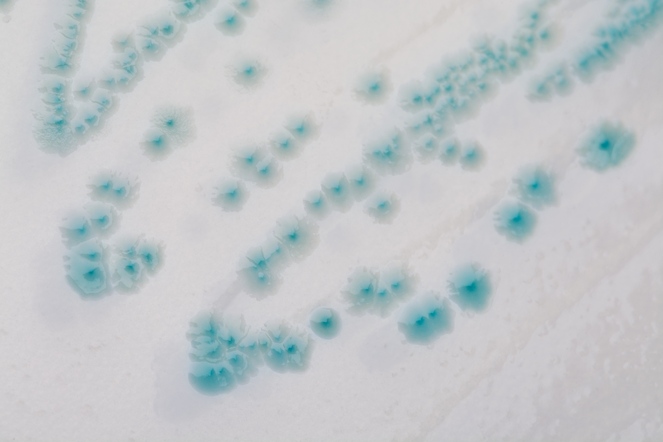

Co je ClearMilk test
- Nejdostupnější diagnostický systém mastitid dojnic
- Určení původců mastitid přímo na farmě
- Rychlá depistáž dojnic vylučujících patogeny
- Dříve prodávaný jako PureMilk test
Proč ClearMilk test
• Stanovení druhu původců mastitidy
• Nastavení efektivní terapie a prevence
• Snížení spotřeby antibiotik
• Úspora nákladů v rámci antimastitidního programu a zaprahování dojnic
Z čeho se ClearMilk test skládá
• Třísektorová Petriho miska s chromogenními agary • Zkumavka pro odběr mléka • Bakteriologická klička pro nanesení mléka na Petriho misku • Ubrousek pro desinfekci hrotu struku před odběrem vzorku
Jak použít ClearMilk test
- Odeberte vzorek mléka do zkumavky.
- Naneste vzorek mléka inokulační kličkou na povrch všech tří agarů Petriho misky.
- Inkubace CM testu je 22–26 hodin při teplotě 37,5°C.
- Stanovte druh původu mastitidy s pomocí našeho Atlasu původců
Návazná laboratorní vyšetření
• Laboratorní vyšetření navazující na faremní diagnostiku pomocí ClearMilk testu slouží ke kontrole správnosti zjištěných původců (např. při prvním použití CM testu) a také k identifikaci mikroorganismů, které podle atlasu původců na farmě sami neurčíte. • Diagnostika je prováděna na moderním přístroji MALDI-TOF a výsledek získáme do několika hodin. • Dalším důležitým vyšetřením, které naše mikrobiologická laboratoř poskytuje, je stanovení citlivosti na používaná antibiotika.
Mastitida mléčného skotu

Proč se obrátit na odborníka?
- Stanovíte seznam patogenů mléčné žlázy CM testem prováděným přímo na farmě
- Potvrdíte určení zjištěných patogenů pomocí MALDI-TOF v naší laboratoři
- Získáte přehled o citlivosti či případné rezistenci na antibiotika pro jednotlivé patogeny vyskytující se na Vaší farmě
- Naučíte se kontrolovat účinnost opatření CM testem
- Budete mít dostupnou konzultaci v případě potřeby

Nová legislativa k omezení ATB
Nová legislativa omezující podávání antibiotik bude zaváděna od ledna 2022. Připravte se na novou situaci zajištěním ClearMilk testů pro diagnostiku a prevenci. Pomozte omezit nadměrné používání antibiotik a rostoucí antibiotickou rezistenci v populaci.



